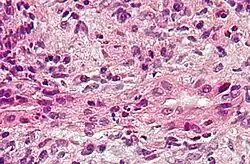
Description de cette image, également commentée ci-après

Cholangite biliaire primitive
(cirrhose biliaire primitive)
| Médicament | Pénicillamine, acide ursodesoxycholique, acide obéticholique, acide ursodesoxycholique et Elafibranor |
|---|---|
| Spécialité | Gastro-entérologie |
| CIM-10 | K74.3 |
|---|---|
| CIM-9 | 571.6 |
| OMIM | 109720 |
| DiseasesDB | 10615 |
| MedlinePlus | 000282 |
| eMedicine | 171117 |
| MeSH | D008105 |
| Patient UK | Primary-biliary-cirrhosis-pro |
![]() Mise en garde médicale
Mise en garde médicale
La cholangite biliaire primitive ou CBP (autrefois nommée cirrhose biliaire primitive[1],[2]) est une maladie chronique, inflammatoire des petites voies biliaires intrahépatiques. Le terme de cirrhose est inapproprié. Elle est absente ou ne se développe pas lors de l'évolution chez la majorité des malades.
Historique
La première description en a été faite par Thomas Addison, avec Gull W, en 1851[3], et Victor Hanot en 1876. Elle reçoit de nouvelles appellations dans les années 1950[2]. Le rôle diagnostique fondamental des anticorps antimitochondries a été mis en évidence en 1965[4]. Lors de l'International Liver Congress 2014 à Londres, il a été proposé de changer de nouveau le nom de la maladie tout en conservant son acronyme (CBP/PBC). Le nom retenu et adopté[1],[2] par les associations savantes — The American Association for the Study of Liver Diseases, AASLD, The European Association for the Study of the Liver, EASL, The International Association for the Study of the Liver, IASL, etc. — est : « Primary Biliary Cholangitis », en français « cholangite biliaire primitive ».
Épidémiologie
La maladie touche principalement les femmes (90 % des cas)[5]. La cholangite biliaire primitive est une maladie rare, dont la prévalence est comprise entre 40 et 400 cas par million d'individus[6]. Elle débute en général entre 35 et 55 ans. Elle est plus fréquente en Europe du Nord et aux États-Unis[7]. Elle semble plus fréquente également en cas d'infections urinaires récidivantes[8]. Le tabagisme et l'utilisation de certains cosmétiques pourraient être des facteurs de risque[9].
Il existe une prédisposition génétique avec un risque augmenté de développer la maladie chez les porteurs de certains variants du complexe majeur d'histocompatibilité de type II, sur deux gènes intervenant dans la synthèse de l'interleukine-12[10] ainsi que sur d'autres gènes (IL21, IL21R, CTLA4, CD58, ARID3A, IL16[11]).
La prévalence des porteurs d'anticorps anti-mitochondrie serait d'environ 0,5 %[12], soit dix fois plus que la fourchette haute de la prévalence de la maladie.
Cause
Il s'agit probablement d'une maladie auto-immune, mais la forte proportion de personnes ayant des anticorps anti-mitochondrie et ne présentant pas la maladie plaide pour une cause multifactorielle. Ainsi des facteurs chimiques ou infectieux pourraient intervenir, possiblement par similitude avec l'auto-antigène[5]. De plus, l'absence de corrélation entre la gravité de la maladie et le taux d'anticorps anti-immun, l'absence d'efficacité d'un traitement immunosuppresseur et l'existence de rares formes de la maladie sans auto-anticorps font douter de l'aspect uniquement auto-immun de la maladie[5].
Clinique
Pendant une longue période (5 à 10 ans), seules des anomalies biologiques peuvent permettre un diagnostic précoce.
La phase symptomatique associe asthénie dans près de la moitié des cas[13] à des signes de cholestase : prurit, ictère.
Les manifestations extra-hépatiques les plus fréquentes (un tiers des cas[5]) sont de type auto-immunes :
- le syndrome de Goujerot-Sjögren ;
- la maladie de Raynaud ;
- manifestations rhumatologiques de type rhumatisme inflammatoire ;
- manifestations cutanées de type sclérodermie. Le syndrome de Reynolds est défini par l'association d'une cholangite biliaire primitive et d'une sclérodermie (généralement limitée, type CREST) ;
- toutes les maladies auto-immunes peuvent s'associer entre elles.
Examens complémentaires
La cholestase biologique associe une augmentation des phosphatases alcalines, des gamma-GT et de la bilirubine conjuguée. L'augmentation des transaminases est modérée sauf dans les formes appelées syndrome de chevauchement hepatite autoimmune-CBP.
Les anticorps anti-mitochondrie sont présents dans 95 % des cas, dès le début de la maladie[14], à un titre souvent élevé. Ils peuvent être associés à des anticorps anti-nucléaires aspect circulaire. Il existe une élévation du taux des immunoglobulines M non spécifiques[15].
L'imagerie est peu parlante, non spécifique mais permet d'éliminer une cirrhose biliaire non primitive, de mécanisme obstructif ou une cholangite sclérosante primitive.
La biopsie hépatique signe le diagnostic, mais est rarement pratiquée, surtout dans les cas où les anticorps anti-mitochondrie font défaut. L'examen histologique montre alors des lésions de cholangite et des altérations des voies biliaires interlobulaires[5].
Évolution
L'évolution se fait en quatre stades.
- Stade asymptomatique avec tests hépatiques normaux. Le diagnostic peut être fait sur la présence d'anticorps anti-mitochondrie.
- Stade asymptomatique avec tests hépatiques anormaux : augmentation des phosphatases alcalines et des transaminases.
- Stade symptomatique avec prurit et asthénie.
- Stade de cirrhose décompensée avec ascite, hémorragies digestives, ictère.
Traitement
La prise en charge de la maladie a fait l'objet de la publication des deux recommandations, l'une par l’European Association for the Sudy of the Liver datant de 2017[16] et l'autre, par l’American association for the study of liver diseases[17], datant de 2018.
Immunosuppresseurs, glucocorticoïdes, colchicine n'apportent qu'un bénéfice faible dans la forme habituelle de la maladie, mais peuvent être néanmoins utiles dans certaines circonstances (formes avec signes d'hépatite auto-immune).
L'acide ursodésoxycholique (Ursodiol) pris en continu, le plus précocement possible, à la dose de 13-15 mg/kg/j, est le traitement de base de la maladie. Les résultats sont plus discutés sur l'évolution à long terme[18],[19]. Cependant, 30 % des patients ont une amélioration insuffisante des tests biologiques ce qui justifie d'autres mesures thérapeutiques afin d'éviter l'évolution vers la cirrhose[20].
Les fibrates semblent apporter un bénéfice[21], mais l'expérience reste limitée.
Tous les traitements symptomatiques et la prise en charge spécifique des complications sont indispensables.
Les agonistes du récepteur farnésoïde X[22], comme l'acide obéticholique (Ocaliva) qui permet d'améliorer la biologie hépatique de ces patients[23], et des PPAR (Elafibranor) semblent avoir des résultats prometteurs. l'AMM du médicament (Ocaliva) a été abrogée pour insuffisance bénéfice risque par l'U.E.(EMA) le 7 août 2024.De source Vidal du 4 septembre 2024.
Dans les formes graves, une transplantation hépatique peut être proposée. La maladie peut cependant récidiver sur le greffon, mais l'évolution est habituellement favorable[5].
Notes et références
- 1 2 « CBP – cholangite biliaire primitive – finalement le changement du nom ! », sur albi-france.org, Association albi, (consulté le ).
- 1 2 3 (en) Ulrich Beuers et al., « Changing nomenclature for PBC: From ‘cirrhosis’ to ‘cholangitis’ », Journal of Hepatology, vol. 63, no 5, , p. 1285-1287 (présentation en ligne).
- ↑ (en) T. Addison et W. Gull, « On a certain affection of the skin, Vitiligoidea—α plana, β tuberosa. With remarks and plates », Guys Hosp Rep, no 7, , p. 265-276.
- ↑ (en) J. G. Walker, D. Doniach, I. M. Roitt et S. Sherlock, « Serological tests in diagnosis of primary biliary cirrhosis », Lancet, no 285, , p. 827-831.
- 1 2 3 4 5 6 (en) C. Selmi, C. L. Bowlus, M. E. Gershwin et R. L. Coppel, « Primary biliary cirrhosis », Lancet, no 377, , p. 1600-9. (PMID 21529926, DOI 10.1016/S0140-6736(10)61965-4, présentation en ligne).
- ↑ (en) M. M. Kaplan et M. E. Gershwin, « Primary biliary cirrhosis », N Engl J Med, no 353, , p. 1261-1273 (lire en ligne).
- ↑ (en) C. Selmi, P. Invernizzi, M. Zuin, M. Podda et M. E. Gershwin, « Genetics and geoepidemiology of primary biliary cirrhosis : following the footprints to disease etiology », Semin Liver Dis, no 25, , p. 265-280.
- ↑ (en) A. K. Burroughs, I. J. Rosenstein, O. Epstein, J. M. Hamilton-Miller, W. Brumfitt et S. Sherlock, « Bacteriuria and primary biliary cirrhosis », Gut, no 25, , p. 133-137 (présentation en ligne).
- ↑ (en) M. I. Prince, S. J. Ducker et O. F. James, « Case-control studies of risk factors for primary biliary cirrhosis in two United Kingdom populations », Gut, no 59, , p. 508-512 (présentation en ligne).
- ↑ (en) G. M. Hirschfield, Liu Xiangdong, Xu Chun et al., « Primary biliary cirrhosis associated with HLA, IL12A, and IL12RB2 variants », N Eng J Med, no 360, , p. 2544-2555 (présentation en ligne).
- ↑ Qiu F, Tang R, Zuo X et al. A genome-wide association study identifies six novel risk loci for primary biliary cholangitis, Nat Commun, 2017;814828
- ↑ (en) A. Mattalia, S. Quaranta, P. S. Leung et al., « Characterization of antimitochondrial antibodies in health adults », Hepatology, no 27, , p. 656-661.
- ↑ (en) N. Al-Harthy, T. Kumagi, C. Coltescu et G. M. Hirschfield, « The specificity of fatigue in primary biliary cirrhosis: evaluation of a large clinic practice », Hepatology, no 52, , p. 562-570 (présentation en ligne).
- ↑ (en) S. Oertelt, R. Rieger, C. Selmi et al., « A sensitive bead assay for antimitochondrial antibodies : chipping away at AMA-negative primary biliary cirrhosis », Hepatology, no 45, , p. 659-665 (présentation en ligne).
- ↑ (en) Lleo A, Wang GQ, Gershwin ME, Hirschfield GM, « Primary biliary cholangitis », Lancet, vol. 396, no 10266, , p. 1915–26. (PMID 33308474, DOI 10.1016/S0140-6736(20)31607-X, lire en ligne)
- ↑ (en) Hirschfield GM, Beuers U, Corpechot C et al., « EASL clinical practice guidelines: the diagnosis and management of patients with primary biliary cholangitis », J Hepatol, vol. 67, no 1, , p. 145-72. (PMID 28427765, DOI 10.1016/j.jhep.2017.03.022, lire en ligne)
- ↑ Lindor KD, Bowlus CL, Boyer J, Levy C, Mayo M, Primary biliary cholangitis: 2018 practice guidance from the American Association for the Study of Liver Diseases, Hepatology, 2019;69:394-419
- ↑ (en) Y. Gong, Z. Huang, E. Christensen et C. Gluud, « Ursodeoxycholic acid for patients with primary biliary cirrhosis : an updated systematic review and meta-analysis of randomized clinical trials using Bayesian approach as sensitivity analyses », Am J Gastroenterol, no 102, , p. 1799-1807 (présentation en ligne).
- ↑ (en) K. D. Lindor, T. M. Therneau, R. A. Jorgensen, M. Malinchoc et E. R. Dickson, « Effects of ursodeoxycholic acid on survival in patients with primary biliary cirrhosis », Gastroenterology, no 110, , p. 1515-1518 (présentation en ligne).
- ↑ (en) U. Beuers, M. Trauner, P. Jansen et R. Poupon, « New paradigms in the treatment of hepatic cholestasis: From UDCA to FXR, PXR and beyond », J Hepatol, vol. 62, no 1S, , S25-S37. (PMID 25920087, DOI 10.1016/j.jhep.2015.02.023, lire en ligne [html], consulté le ).
- ↑ Honda A, Ikegami T, Nakamuta M et al. Anticholestatic effects of bezafibrate in patients with primary biliary cirrhosis treated with ursodeoxycholic acid, Hepatology, 2013;57:1931-1941
- ↑ (en) A. Mason, V. Luketic, K. Lindor et al., « Farnesoid-X receptor agonists : a new class of drugs for the treatment of PBC? An international study evaluating the addition of INT-747 to ursodeoxycholic acid », J Hepatol, no 52 (supplément 1), , p. S1-S2 (présentation en ligne).
- ↑ (en) Nevens F, Andreone P, Mazzella G et al., « A placebo-controlled trial of obeticholic acid in primary biliary cholangitis », N Engl J Med, vol. 375, , p. 631-43. (PMID 27532829, DOI 10.1056/NEJMoa1509840, lire en ligne)
Liens externes
- Page spécifique sur Orphanet.
- FILOIE Filière de santé dédiée aux maladies rares du foie
- Association ALBI Association pour la lutte contre les maladies inflammatoires du foie et des voies biliaires
- Portail de la médecine